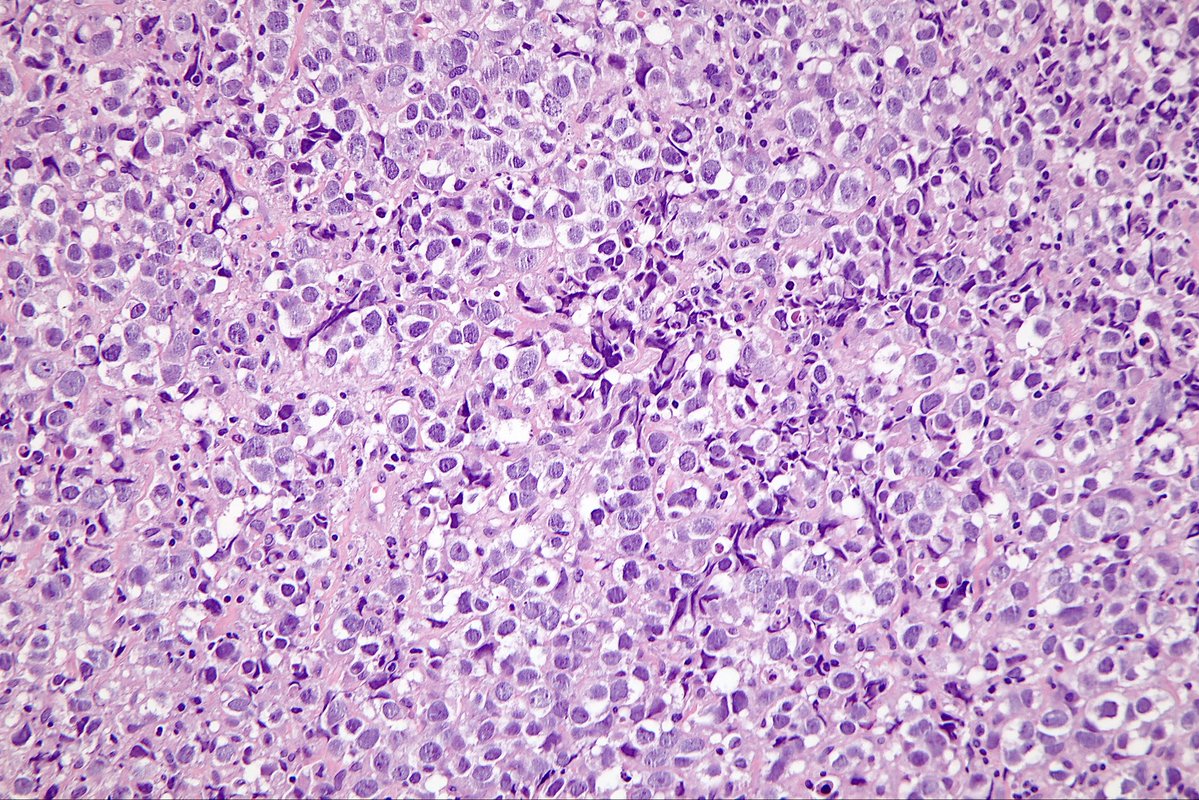
Surgical Pathology Cases tweet media

Surgical Pathology Cases
127 posts

Surgical Pathology Cases
@surgpathcases
Nícollas Fujimoto Surgical pathologist 🇧🇷 List of cases posted ↓↓↓ https://t.co/oczyNRNQKO
Katılım Mart 2024
383 Takip Edilen953 Takipçiler

@bboncodd @SumantaDas_7 AE1/AE3, CK8/18, 34BE12, and CK5/6 were all negative.
👇 CK8/18 and 34BE12


English

@surgpathcases @SumantaDas_7 😳are you sure?? ca was excluded here?
English